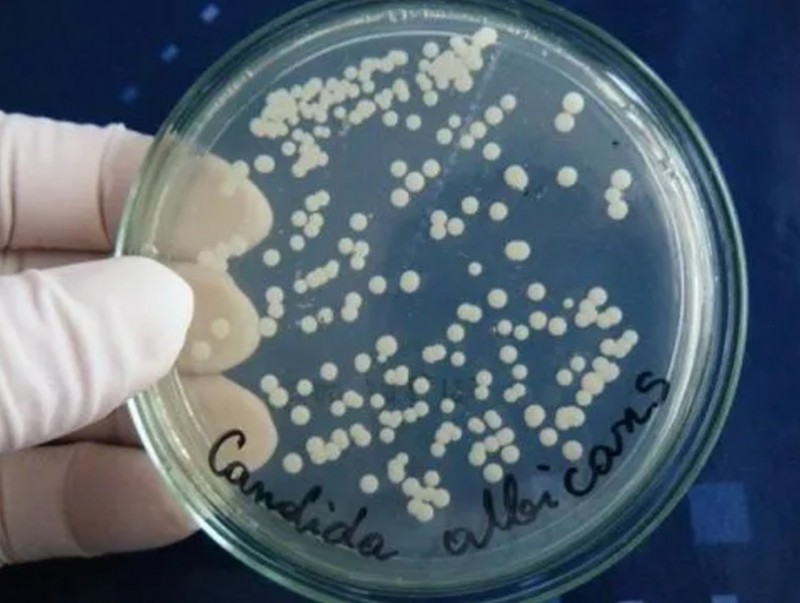

MNB Монголын Мэдээ суваг үзүүлж байна: Сумын сургууль мөөгөнцөртэй барилгад хичээллэж байна
| Сумын сургууль мөөгөнцөртэй барилгад хичээллэж байна | ||
| Үзсэн: 547 | Mongolian National Broadcaster |
MNB Монголын Мэдээ суваг үзүүлж байна: Сумын сургууль мөөгөнцөртэй барилгад хичээллэж байна
| Сумын сургууль мөөгөнцөртэй барилгад хичээллэж байна | ||
| Үзсэн: 547 | Mongolian National Broadcaster |
























































































































Сэтгэгдэл бичих:
АНХААРУУЛГА: Уншигчдын бичсэн сэтгэгдэлд MNB.mn хариуцлага хүлээхгүй болно. ТА сэтгэгдэл бичихдээ хууль зүйн болон ёс суртахууны хэм хэмжээг хүндэтгэнэ үү. Хэм хэмжээг зөрчсөн сэтгэгдэлийг админ устгах эрхтэй. Сэтгэгдэлтэй холбоотой санал гомдолыг 70127055 утсаар хүлээн авна.